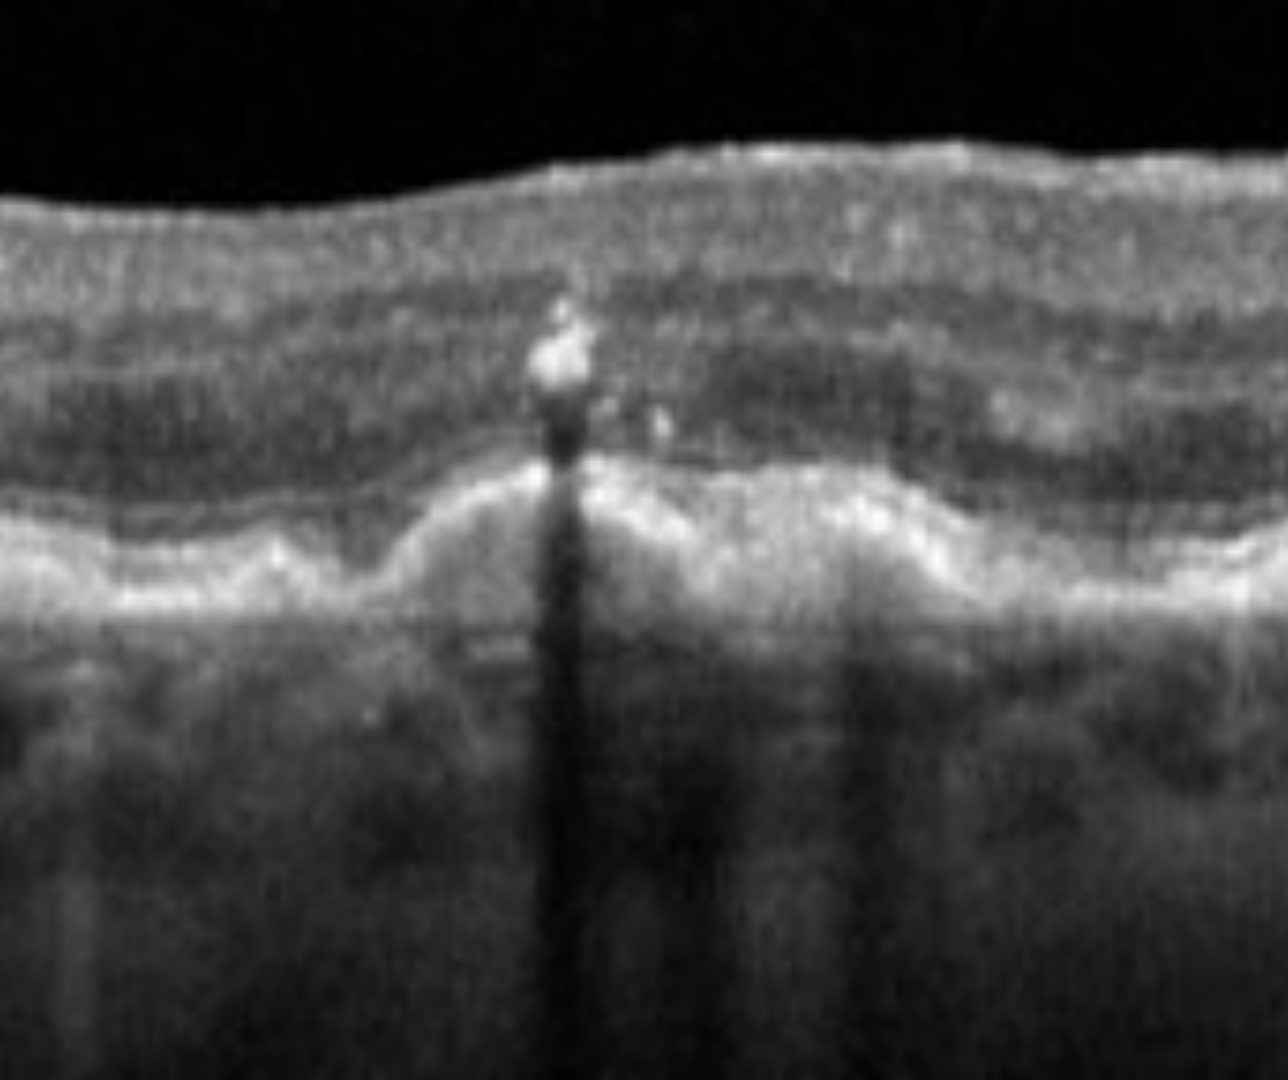

- Overview
- Prognostic biomarkers (high strength of evidence)
- Other potential prognostic biomarkers
- Related Topics
- References
Overview
The advent of OCT imaging allows clinicians to identify structural risk factors for progression in intermediate AMD. The identification of these biomarkers can help risk stratification and subsequently allow tailored and individualized management plans.
This is an area of research that is constantly evolving and we present here risk factors that may predict a higher risk of progression which are supported by the current evidence base.
Prognostic biomarkers (high strength of evidence)
-
Drusen Volume
High drusen volume at the macula is the strongest risk factor for AMD progression.
A drusen volume greater than or equal to 0.03mm³ within a 3mm central circle is associated with a four-fold increase in progression risk from intermediate to late AMD when compared with drusen volume less than 0.03mm³ (Abdelfattah et al. 2016).
Drusen volume can be established qualitatively (a higher number of visible drusen at the macula confers a higher risk of progression), or quantitatively using some commercially available OCT software.
It is worth noting that as AMD progresses, drusen can fade and spontaneously regress. When drusen regression occurs, there may be no residual signs apart from pigment mottling and it may not affect visual acuity, however there is a higher risk of conversion to late AMD (geographic atrophy).
-
Reticular pseudodrusen
Reticular pseudodrusen (RPD) are deposits in the sub-retinal space (above the RPE) and are distinct from conventional drusen which are located underneath the RPE. On FAF imaging, they present with an interlacing or reticular pattern. They can be associated with progression to both forms of late AMD.
A 2024 update to the AREDS Simplified severity scale attempts to quantify the increased risk associated with the presence of RPD, stratifying risk for patients with and without RPD. This is explored in more detail on the link "Clinical Classification of AMD" at the bottom of this page.
Other potential prognostic biomarkers
-
Hyper-reflective foci
Hyper-reflective foci appear as a dot-like intraretinal hyper-reflective lesion at the apex of drusen. They typically correspond to pigmentary abnormalities on funduscopic examination. Its presence is associated with a 5-fold increased risk of progression to geographic atrophy at 2 years.
-
Nascent geographic atrophy (incomplete RPE and outer retinal atrophy)
Nascent GA is characterised by the subsidence of the outer plexiform (OPL) and inner nuclear layer (INL) and/or hyporeflective wedge shaped band within the limits of the OPL. They are typically located in the central 1500m of the macula.
Nascent geographic atrophy may also termed IRORA (incomplete retinal pigment epithelium and outer retinal atrophy). Its presence is associated with impending geographic atrophy.
-
Hypo-reflective drusen cores
Hypo-reflective or darker areas within drusen cores seen on OCT
-
Altered Integrity of Outer Retinal Hyper-reflective Bands
Interruptions in hyper-reflectivity, irregularity or attenuation of the External limiting membrane (ELM), ellipsoid zone (EZ) or interdigitation zone (IZ) can indicate a higher chance of progression to late AMD, specifically neovascular AMD
References
1. Abdelfattah NS, Zhang H, Boyer DS, Rosenfeld PJ, Feuer WJ, Gregori G, Sadda SR. Drusen Volume as a Predictor of Disease Progression in Patients With Late Age-Related Macular Degeneration in the Fellow Eye. Invest Ophthalmol Vis Sci. 2016 Apr;57(4):1839-46. doi: 10.1167/iovs.15-18572. PMID: 27082298.
2. Agrón E, Domalpally, A Chen, Q Lu Z. Chew EY. Keenan TDL. (2024) An Updated Simplified Severity Scale for Age-Related Macular Degeneration Incorporating Reticular Pseudodrusen: Age-Related Eye Disease Study Report Number 42, Ophthalmology, 2024, https://doi.org/10.1016/j.ophtha.2024.04.011.
3. Guymer R, Wu Z. Age-related macular degeneration (AMD): More than meets the eye. The role of multimodal imaging in today's management of AMD-A review. Clinical & experimental ophthalmology. 2020;48(7):983-95.
4. Trinh M, Cheung R, Duong A, Nivison-Smith L, Ly A. OCT prognostic biomarkers for progression to late age-related macular degeneration: A systematic review and meta-analysis. Ophthalmology Retina. 2023.